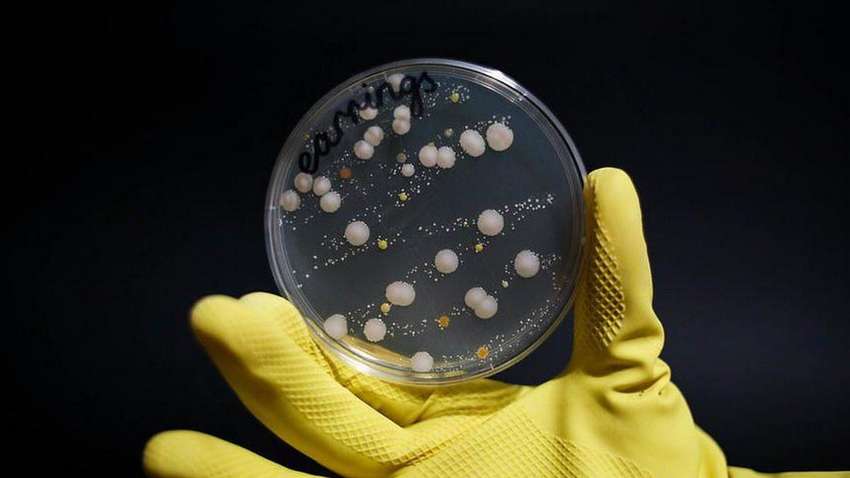
Ученые показали, сколько микробов живет на украшениях Ученые показали, сколько микробов живет на украшениях

Рубрики
МЕНЮ
Светлана Шкурупий
Пожалуй, все знают о том, что микробы и вирусы могут жить на различных поверхностях, в том числе и на украшениях. Многие люди часто забывают очищать свои аксессуары, не задумываясь о том, сколько бактерий там может скапливаться. Ученые решили наглядно показать, как выглядят украшения, если не чистить их одну неделю. Результатами эксперимента поделилось издание Dailymail.
Исследователи доказали, что на серьгах, кольцах, часах и других аксессуарах может жить в 400 раз больше бактерий, чем на сиденье унитаза. Ученые изучили поверхность украшений и обнаружили на них до 21 тысяч различных бактерий. Самой опасной из них оказался золотистый стафилококк, который может вызвать сепсис или пневмонию.
На кольце, ученые обнаружили более 500 колоний бактерий. Среди них была черная плесень, споры которой могут попасть в организм через дыхательные пути. А вот на серьгах найдена "восковая" бактерия, которая способна вызвать тяжелое отравление. На часах было не меньше микробов, чем на аксессуарах — до 21 тыс. колоний.
Ранее издание "Комментарии" сообщало, на каких банкнотах живет больше всего бактерий.